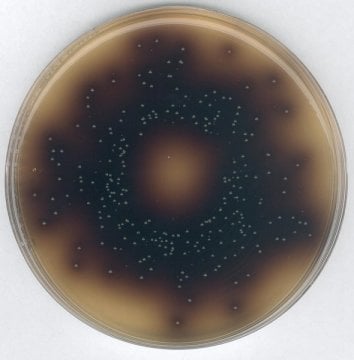
Merck 100072 Bile Aesculin Azide Agar, Acc. To Iso 7899-2 For Microbiology  500 gr

| MERCK 100072 Bile Aesculin Azide Agar, acc. to ISO 7899-2 for microbiology 500 gr | |
|---|---|
| Catalogue Number | 100072 |

| Product Information | |
|---|---|
| HS Code | 3821 00 00 |
| Quality Level | MQ100 |
| Physicochemical Information | |
|---|---|
| pH value | 6.9 - 7.3 (54.85 g/l, H₂O, 25 °C) (after autoclaving) |
| Solubility | 54.85 g/l |
| Storage and Shipping Information | |
|---|---|
| Storage | Store at +15 °C to +25 °C. |

Harmful
Harmful